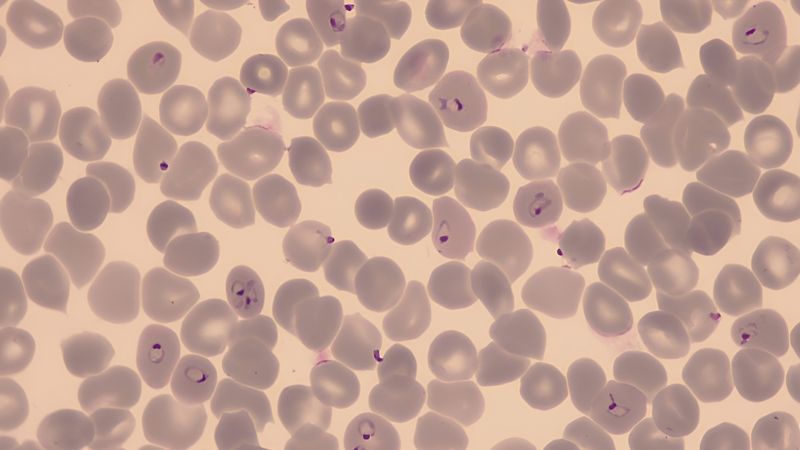
Red blood cells infected with Plasmodium falciparum

Search
Vesa Kopliku
delivery of nucleic acid therapeutics and innovative drug candidates, with the aim of enabling more robust, effective and accessible treatments in advanced drug and gene delivery. [...] HIPS as an Erasmus+ exchange student, where she…
Read moreAnna Priester
Assistant to the Head of the Departments Clinical Bioinformatics , Drug Bioinformatics , Human-microbe Systems Bioinformatics , and Data Driven Drug Design Assistant to the Management of the PharmaScienceHub Central
Read moreMission
Tabea Trampert
University and then worked in Innovative Electron Microscopy. Since August 2021, she has been part of the "Drug Transport across Biological Barriers" team at HIPS. Her focus is on primary cell isolation from tissue [...] blood-air barrier…
Read moreLeon Schwarz
Prof. Claus-Michael Lehr, pertained the usage of lanthipeptides for cancer cell targeting in a novel drug delivery model based on encapsulin. Since 2024, he is working towards his PhD in a joint project between [...] Hubrich, the topic…
Read moreADMET
Dr Mostafa Hamed
of Drug Design and Optimization (DDOP). He is a medicinal chemist whose research focuses on the development of novel anti-infective and antivirulence agents, and has contributed to multiple drug discovery
Read more